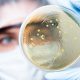

Produkty czy też środki biobójcze to gama preparatów wykorzystujących substancje o działaniu biobójczym. Co to jednak dokładnie znaczy? Czy są to wyłącznie środki do zwalczania owadów? A może środek do zwalczania grzyba na ścianie i środek do zwalczania grzybów atakujących rośliny również łapią się do tej kategorii? W dzisiejszym artykule wyjaśnimy Ci podstawowe pojęcia i podamy zakres definicji środków biobójczych. Zapraszamy!
Produkty i środki biobójcze to różnego rodzaju preparaty służące do zwalczania organizmów po pierwsze szkodliwych dla życia bądź zdrowia ludzi, zwierząt czy też środowiska, po drugie zaś powodujących szkody w działalności człowieka, np. uprawie roślin, budownictwie. Środki biobójcze przeciwdziałają dużym organizmom uważanym za szkodniki (np. szczurom bądź kretom), małym organizmom (owadom), a także mikroorganizmom: bakteriom, wirusom, pleśni, grzybom.
O składzie, którym muszą odznaczać się środki biobójcze, przeczytasz tutaj: Produkty biobójcze – co to jest i jakie wymogi muszą spełniać, by zostały zarejestrowane?
Wśród najpopularniejszych środków biobójczych znajdują się:
Warto wiedzieć, że środek biobójczy to nie tylko preparat, którego główną bądź jedyną funkcją jest przeciwdziałanie zgubnej aktywności szkodników. Za produkt biobójczy uważa się również preparat, którego jedną z cech jest biobójczość. Dobry przykład stanowi impregnat biobójczy do drewna, który ma chronić drewniane konstrukcje jednocześnie przed wilgocią, promieniowaniem UV, owadami, mchami i mikroorganizmami. Dodatkowe działanie biobójcze wykazują np. środki do konserwacji drewna, materiałów włókienniczych, tworzyw sztucznych. Są to impregnaty, farby, bazy i inne produkty.
Uwaga: zarówno same środki biobójcze, jak i produkty z dodatkiem środków biobójczych mogą zawierać wyłącznie takie substancje czynne, które zostały w tym celu zatwierdzone w Unii Europejskiej.
Środki biobójcze to produkty o kolosalnym znaczeniu dla życia i zdrowia ludzi, zwierząt oraz roślin. Chronią przed poważnymi chorobami takimi jak malaria, denga, salmonelloza czy listerioza. Zabezpieczają przed zakażeniami żywnością, szpitalnymi i mikroorganizmami krążącymi w powietrzu. Czy nie byłoby zatem lepiej, gdyby rejestracja środków biobójczych nie była konieczna, tylko dało się od razu po wyprodukowaniu wypuścić je na rynek?
Zdecydowanie nie, bo chociaż środki biobójcze niosą ogromne korzyści, jednocześnie mogą stanowić zagrożenie dla ludzi, zwierząt i środowiska. Sytuacja byłaby bardzo ryzykowna, zwłaszcza gdyby nie istniały żadne regulacje i procedury weryfikacyjne, dzięki czemu przedsiębiorcy mogliby wprowadzać do obrotu dowolne niebezpieczne substancje. Dlatego potrzebne są regulacje – w Polsce obowiązują zasady unijne i krajowe.
Dla osób, które wcześniej nie miały z nią do czynienia, rejestracja środków biobójczych może wydawać się skomplikowanym procesem. I rzeczywiście, obejmuje szereg czynności, które trzeba wykonać, aby wniosek do Urzędu Rejestracji Produktów Leczniczych, Wyrobów Medycznych i Produktów Biobójczych został oceniony jako kompletny i mógł zostać rozpatrzony.
Na szczęście tutaj pojawiamy się my – firma Polskie Produkty Biobójcze, która za upoważnieniem przedsiębiorców bierze cały proces na siebie. Pilnujemy kompletności dokumentacji, przeprowadzamy wymagane prawnie badania środków biobójczych, pilnujemy terminów i składamy wnioski za naszych klientów.
A co właściwie rejestracja środków biobójczych ma na celu?